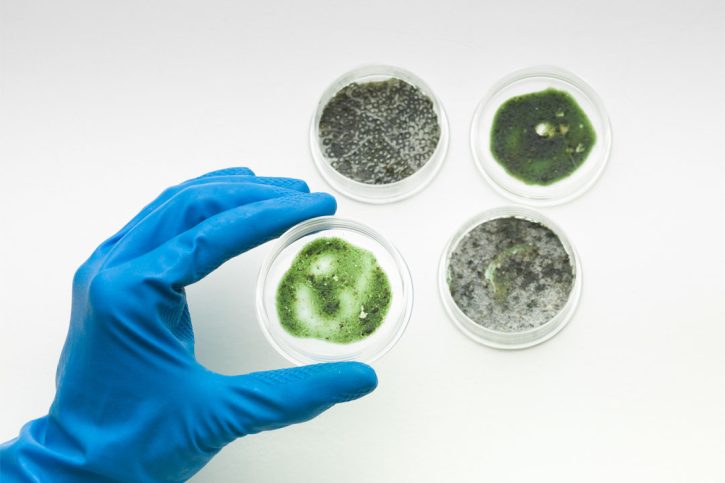
different-types-of-mold

How To Get Mold Out Of Car
Spilling liquids and leaving the windows open on rainy days can all cause mold to grow inside your vehicle. Follow this guide to properly remove mold from your car, safely and effectively. Removing Mold From Your Car Tips Always start this process by completely cleaning out the inside of your car. Gather any items that…